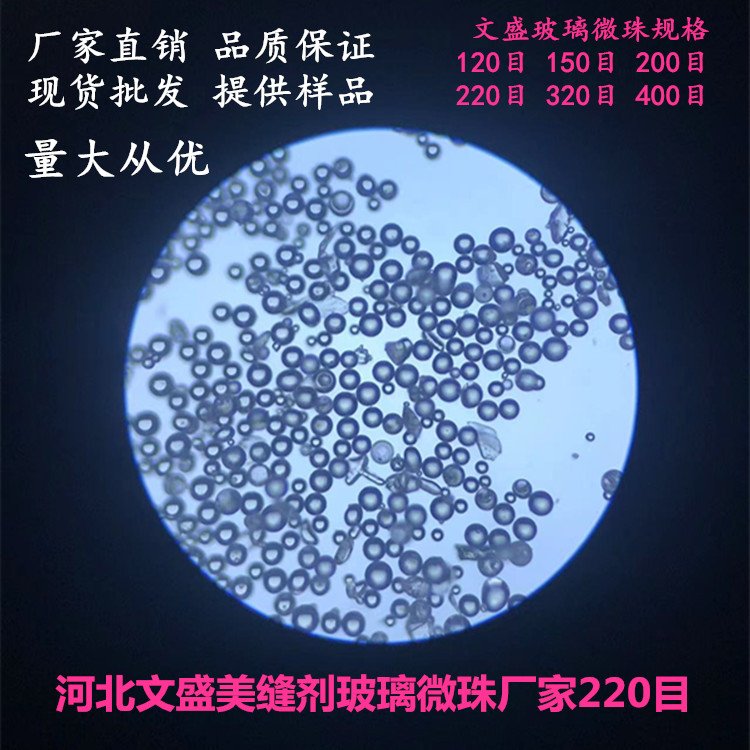
190014_688117_procont.jpg

参考价栻/p>1万元以下
型号
美缝剂玻璃微珟/span>品牌
文盛玻璃微珠产地
河北样本
暂无主成分含量(%):
96制作方法9/p>烧制
密度(kg/m³):
2.2纯度9/p>98
莫氏硬度9/p>7-8
白度9/p>70
目数9/p>220?/span>
品级9/p>一?/span>
留言询价
虚拟号将 180 秒后失效
使用微信扫码拨号
批发220目环氧彩砂美缝剂填充玻璃微珠多规格无杂质
河北文盛新材大量生产环氧彩砂美缝剂专用玻璃微珟/strong>+strong>水性桶装环氧彩砂美缝剂、双管环氧彩砂美缝剂、环氧彩砂填缝剂均是采用高原度不发黑的高品质玻璃微珠作为填充原材料生产的、span style="color:#7030A0">美缝剂玻璃微珟/span>具有吸油率低、高圆度流动性好、分散性好与树脂性好及易于施工和清理+strong>微小球体使美缝剂具有细密的填充和修复作用,美缝剂玻璃微珠外观细腻光滑质感优良是生产高品质彩砂美缝剂的必须原料+/strong>可以定制生产为客户免费提供测试样品,提供生产工艺及配斸/span>,欢迎国内外客户咨询订购、/span>
美缝剂玻璃微珠添加比例多尐/span>9/span>不同产品请咨询使用方法、/span>
彩砂美缝剂玻璃微珠规格:20目?0目?0目?0目?00目?20目?50目?00目?20目?80目?20目?00目等规格+/span>

美缝剂玻璃微珠的主要用途:环氧彩砂美缝剂、彩砂填缝剂、琉砂瓷、双管彩砂美缝剂、聚脲美缝剂填料、勾缝剂、工艺品沙画、沙漏、涂料、墙漆、塑料填充、油漆填充、外墙真石漆、地坪漆、艺术漆、塑料、橡胶、反光材料、饰品、研磨、喷丸、电子产品、礼品装饰、手机壳装饰、新型材斘/span>等产品的生产当中、/span>
美缝剂玻璃微珠颜艱/span>9/span>30个日常应用颜色,可以定制多种颜色(定制颜色五百公斤?、/span>
美缝剂玻璃微珠属性:
1?/span>成分:硼硅酸?nbsp; CAS号:65997-17-3 Glass beads
2?/span>化学成分:SiO2 >67%, CaO>8.0% MgO>2.5% Na2O<14%, al2o3="" 0.5-2.0="" fe2o3="">0.15其他2.0%
3?/span>密度9/span>2.4-2.6 g/cm3,堆积密??.5 g/cm3、/span>
4?/span>莫氏硬度: 6-8莫氏
5、粒径:38-800um
6?/span>温度?000
7?/span>规格?0?400?/span>
8?/span>包装?5kg/袊/span>
9?/span>外观:光洁、圆整、无杂质圆形玻璃球体
10?/span>成圆率:?5%以上
11?/span>英文名:Glass beads
12?/span>磁性粒子不超过产品重量?.1%
13?/span>玻璃珠珠体内气泡含量低于10%
14?/span>不含有任何硅树脂类成仼/span>
文盛美缝剂玻璃微珟/strong>采用高品质玻璃颗粑/span>经高温烧制而成,颜色久,不掉色,耐酸碱,可耐高?00度,各种规格粒径均匀,颗粒浑圆颜色丰富多彩久靓丽环保与各种树脂兼容性好,具有很好的颜色牢固性、耐酸性,耐化学溶剂性,耐热水性、低吸油率等特点。广泛应用于多类产品中,材料是由硼硅酸盐原料经高科技工艺处理加工而成,具有比较高的强度、质量轻、低导热、成分稳定性等特点、/span>
彩色玻璃微珠是取代彩砂的原材料产?/span>,可以广泛应用于美缝剂、填缝剂、环氧地坪、墙漆、外墙真石漆、涂料、沙漏的生产。取代彩砂在以上产品中的添加作用,有效提高产品的性能和功效。是彩砂美缝剂、琉砂瓷、双管彩砂美缝剂、填缝剂、涂料、墙漆、外墙真石漆、环氧地坪升级换代产品的理想原材斘/strong>。欢迎厂商拿样试用,玻璃微珠已经在市场取得了良好的应用效果、/span>
沙漏用彩色玻璃微珟/span>,颜色靓丽,其制作流沙不仅计算时间准确,而且流动起来均匀流畅,是普通沙漏用彩砂的升级替代品、/span>
反光高折射玻璃微珠应用于航空航天机械的除锈中,城市交通道路的斑马线、禁停线、双黄线的夜间反光、和交通标志牌的夜间反光装置中
反光玻璃微珠道路公路标线反光?0-40?/span>,反光系?00左右、折射率1.6透明反光玻璃微珠、/span>
批发220目环氧彩砂美缝剂填充玻璃微珠多规格无杂质
暂无数据
高白220目环氧彩砂美缝剂填充玻璃微珠无杂质的工作原理介绍>/li>
高白220目环氧彩砂美缝剂填充玻璃微珠无杂质的使用方法>/li>
高白220目环氧彩砂美缝剂填充玻璃微珠无杂质多少钱一台?
高白220目环氧彩砂美缝剂填充玻璃微珠无杂质使用的注意事项
高白220目环氧彩砂美缝剂填充玻璃微珠无杂质的说明书有吗?
高白220目环氧彩砂美缝剂填充玻璃微珠无杂质的操作规程有吗>/li>
高白220目环氧彩砂美缝剂填充玻璃微珠无杂质的报价含票含运费吗>/li>
高白220目环氧彩砂美缝剂填充玻璃微珠无杂质有现货吗?
高白220目环氧彩砂美缝剂填充玻璃微珠无杂质包安装吗?

